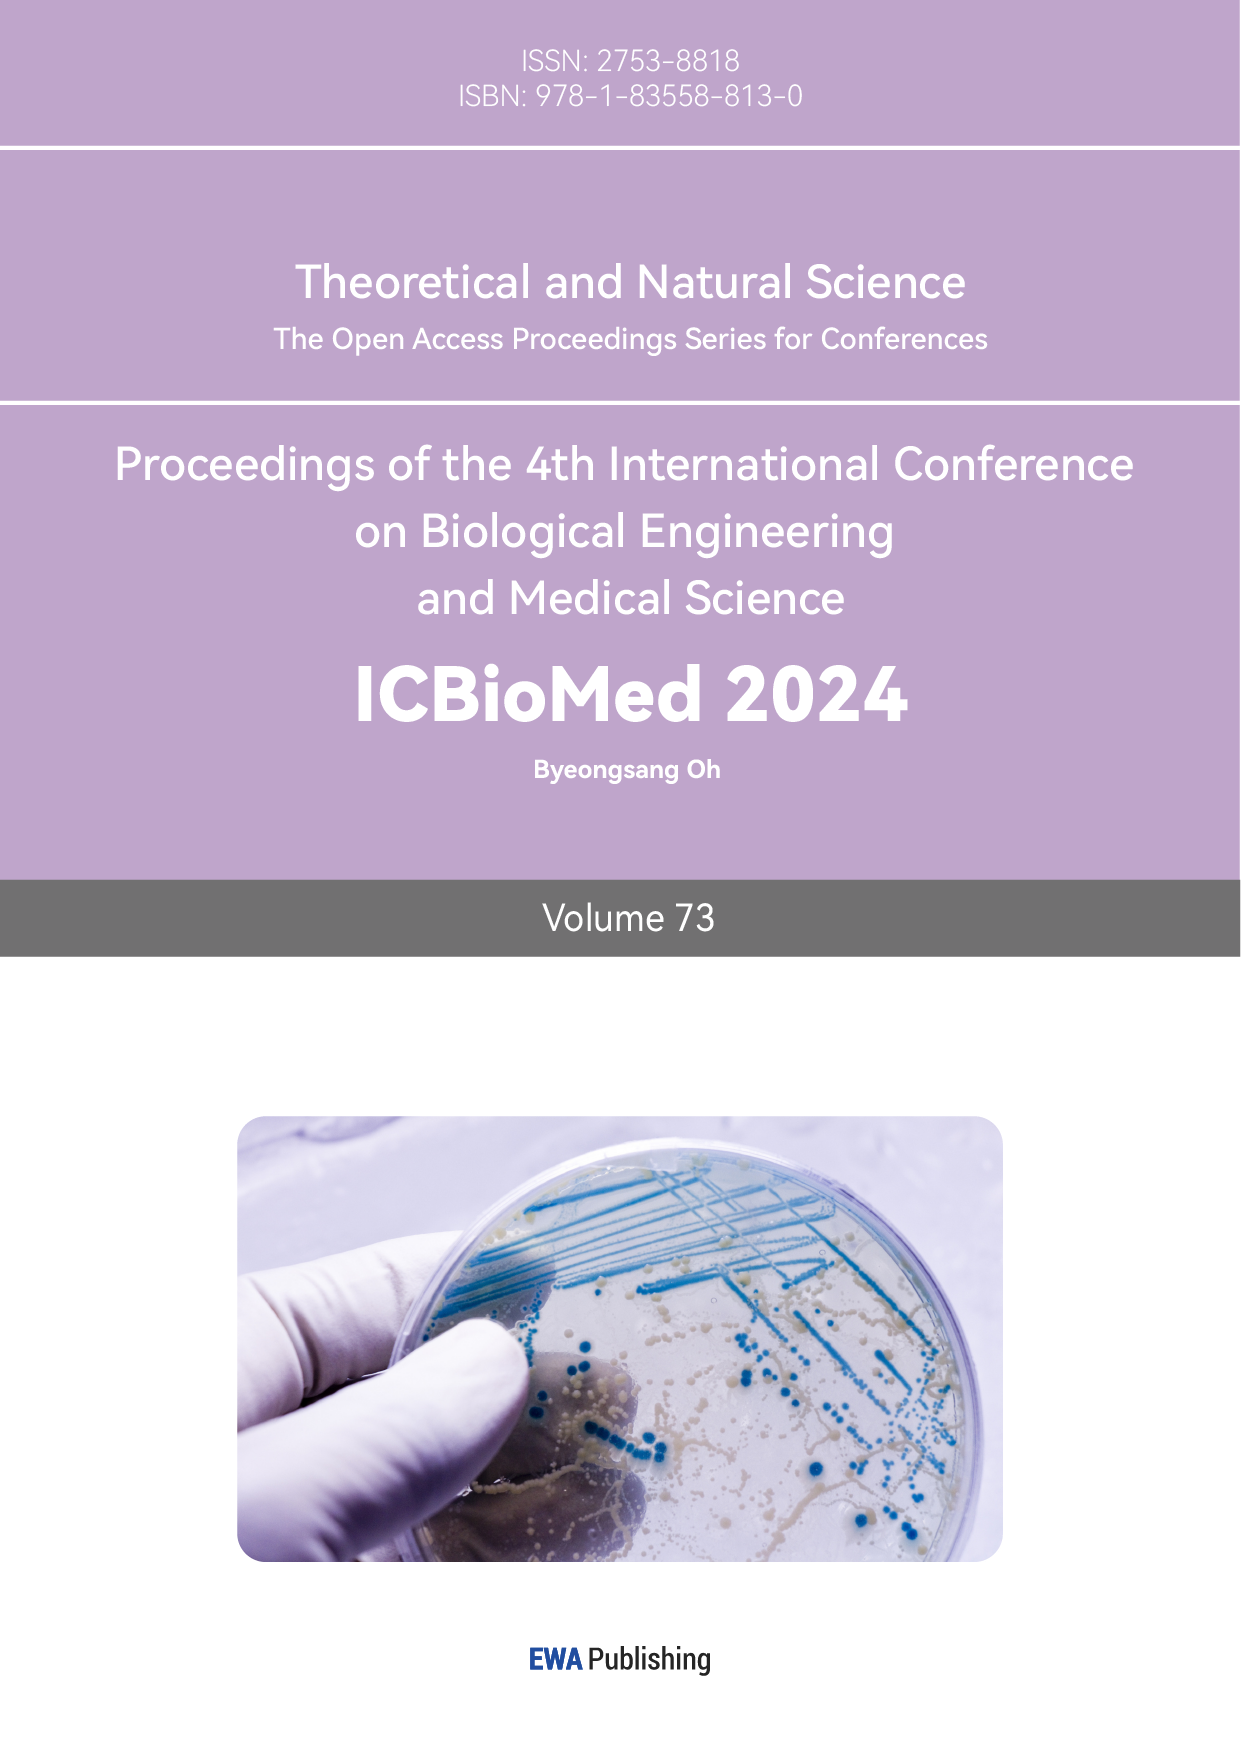
Volume Cover

Article Information
Cite this article
Data availability
The datasets used and/or analyzed during the current study will be available from the authors upon reasonable request.
Disclaimer/Publisher's Note
The statements, opinions and data contained in all publications are solely those of the individual author(s) and contributor(s) and not of EWA Publishing and/or the editor(s). EWA Publishing and/or the editor(s) disclaim responsibility for any injury to people or property resulting from any ideas, methods, instructions or products referred to in the content.
About this Volume
Volume Title: TNS Vol.73
Part of Series: Theoretical and Natural Science
ISSN: 2753-8818 (Print) / 2753-8826 (Online)
Copyright & License
© 2026 by the author(s). Licensee EWA Publishing, Oxford, UK. This article is an open access article distributed under the terms and conditions of the Creative Commons Attribution (CC BY) license.